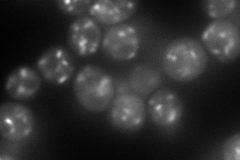
YDR100W
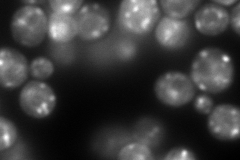
YDR100W
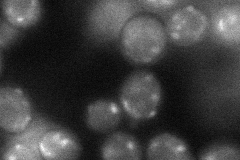
YDR100W

View description
Integral membrane protein localized to late Golgi vesicles along with the v-SNARE Tlg2p
Localization:
Intensity:
Fold change:
Significance:
-
C’ GFP library in SD

punctate54.13 -
N' NOP1pr-GFP in SD
punctate197.33 -
N' TEF2pr-mCherry in SD
punctate357.388 -
N' NATIVEpr-GFP in SD

punctate69.7538 -
N' TEF2pr-VC and Cyto-VN in SD
punctate51.96 -
C’ GFP library in SD+DTT

punctate51.190.94No -
C’ GFP library in SD+H2O2

punctate40.50.74No -
C’ GFP library in Starvation Media

punctate63.071.16No -
C’ GFP library on the background of Pup2-DaMP

punctate -
C’ GFP library on the background of CCT mutant

punctate40.56010.749226No
